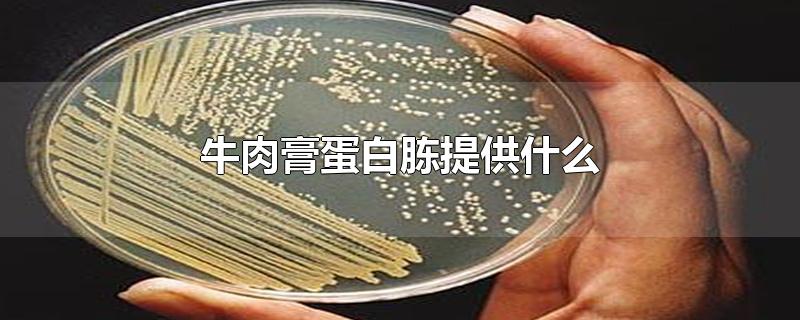

牛肉膏蛋白胨提供什么
牛肉膏蛋白胨提供什么
牛肉膏蛋白胨主要提供碳源,氮源,磷酸盐,维生素和无机盐。牛肉膏蛋白胨是一种琼脂培养基,因为价格相对便宜又容易制作,在微生物培养中有着广泛的应用。
牛肉膏蛋白胨提供什么
由于不同的微生物需要的营养不同,一种培养基不可能适合所有微生物,但牛肉膏蛋白胨培养基提供的营养是大部分微生物都需要的。
牛肉膏蛋白胨培养基在制作与使用过程中需要注意规范使用,防止细菌污染,否则会使培养基失去营养。
在牛肉膏蛋白胨培养基制作过程中可以加入其他营养物质来制成不同的培养基,用来培养不同的微生物。
相关标签:
-

- 牡丹烟331 332 330区别
-
2026-04-21 20:19:14
-

- 名胜古迹的地方有哪些
-
2026-04-21 20:16:59
-

- 美食的有趣经典语录
-
2026-04-21 20:14:44
-

- 洛在女孩名字的含义
-
2026-04-21 20:12:29
-

- 花木兰是什么朝代 可汗 花木兰是什么朝代 那时候有烟花么?
-
2026-04-21 20:10:15
-

- 伞草扦插繁殖方法
-
2026-04-21 20:08:02
-

- 穆阳属于哪个省
-
2026-04-21 18:02:30
-

- 馒头上的红点是什么材料
-
2026-04-21 18:00:16
-

- 马蹄是啥水果
-
2026-04-21 17:58:00
-

- 马肉煮多久能熟
-
2026-04-21 17:55:46
-

- 油碟怎么配料
-
2026-04-21 17:53:33
-

- 野鸭是几级保护动物
-
2026-04-21 17:51:18
-

- 五服怎么划分
-
2026-04-21 17:49:04
-

- 林下参和野山参区别在哪
-
2026-04-21 17:46:49
-

- 水池旁的黑色霉斑怎么去除 如何清除水池边上的霉菌
-
2026-04-21 17:44:34
-

- 裙带属于海鲜吗? 裙带菜属于海鲜
-
2026-04-21 17:42:20
-

- 锡箔纸和铝箔纸有什么区别
-
2026-04-21 15:36:48
-

- 无锡立秋吃什么
-
2026-04-21 15:34:34
-

- 为什么隔夜的马鲛鱼不能吃
-
2026-04-21 15:32:19
-

- 罐装啤酒放冰箱冷冻会爆炸吗
-
2026-04-21 15:30:06



 火车卧铺几点关灯,火车卧铺晚上几点关灯的?
火车卧铺几点关灯,火车卧铺晚上几点关灯的? 日本男演员排名(日本男演员2025)
日本男演员排名(日本男演员2025)